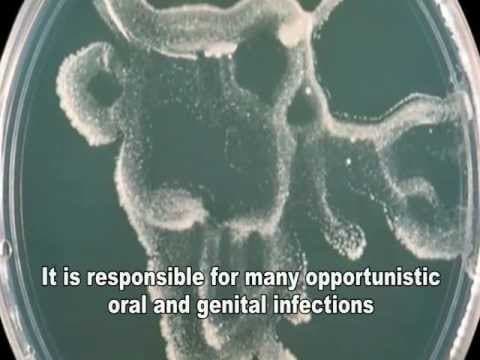
Kandidijaza

Za razliku od ostalih spolno prenosivih bolesti, čiji su simptomi uglavnom ograničeni na genitalni sustav, hepatitis B je bolest koja zahvaća prije svega jetru i označuje difuznu upalu jetre izazvanu hepatitis B virusom - HBV. Spada u najčešće infektivne bolesti, a računa se da je širom svijeta prisutno oko 300 milijuna kroničnih nositelja HBV.
Najčešći put prijenosa je nakon uboda ili posjekotine na zaraženu iglu ili drugi oštar predmet te spolni put. Uporaba nesterilnih i zaraženih šprica i igala odgovorna je za prijenos virus u 30%-60% slučajeva bolesti. Prijenos virusa putem transfuzije krvi nakon uvođenja odgovarajućih testova krvi praktički je prekinut. Prijenos nesterilnim medicinskim instrumentima u razvijenim zemljama izuzetno je rijedak. Bliski obiteljski kontakt s oboljelom osobom moguć je put prijenosa. Pretpostavlja se da se događa pri zajedničkom korištenju pribora za brijanje, četkica za zube ili pri kontaktu s izlučevinama rana. Ne tako neznačajan prijenos infekcije moguć je pri akupunkturi, tatoou ili piercingu ako se rabe nesterilni instrumenti. Način prijenosa infekcije nije moguće utvrditi u 30% oboljelih.
Infektivna čestica virusa (Dane čestica) sastoji se od unutrašnje jezgre / core i vanjskog površinskog omotača / surface. Jezgra sadrži DNA i DNA-polimerazu i replicira se u jezgri inficiranih hepatocita. Površinski omotač stvara se u citoplazmi stanice i iz nejasnih razloga u daleko većoj mjeri nego što je to potrebno. Njegova prisutnost u krvi (HBs-Ag ili Australia Antigen) dokazuje se imunološkim metodama i govori u prilog aktivne hepatitis B infekcije, odnosno infektivnog statusa.
Karakterističan je nalaz ovog antigena još u vrijeme inkubacije, uobičajeno 1 - 6 tjedana prije izbijanja kliničkih ili laboratorijskih znakova bolesti, dok se u vrijeme rekonvalescencije gubi iz krvi. Protutijela protiv ovog antigena javljaju se tjednima ili mjesecima nakon kliničke bolesti i perzistiraju doživotno (Anti-HBs). Unutrašnja jezgra virusa (HBc-Ag) normalno se ne nalazi u serumu, dok nalaz protutijela protiv virusne jezgre (Anti-HBc) upućuje na aktivno razmnožavanje virusa. Ova protutijela su prisutna na početku pojave kliničkih simptoma, potom se njihova razina postupno smanjuje.
Treći antigen koji se nalazi kod ove infekcije je peptid iz virusne jezgre (HBe-Ag), čije je prisustvo značajno u produkciji viralne DNA polimeraze. Nalaz HBe-Ag u serumu označuje jaku virusnu replikaciju i snažnu infektivnost krvi, a govori u prilog visokog rizika za nastajanje kronične bolesti jetara. Suprotno tome nalaz protutijela protiv e-antigena (Anti-HBe) označuje manju infektivnost i uobičajeno vrijedi kao prognostički biljeg za dobroćudni tijek bolesti. Akutni oblik hepatitisa B kod 6 - 10% nositelja virusa prelazi u kronični oblik (carrier-status), dok u dojenačkom i uzrastu malog djeteta ovaj postotak iznosi 60 - 90%. Računa se da su najmanje 1/3 kroničnih nositelja virusa djeca ili odrasli inficirani u dječijoj dobi. U oko 25% ovih pacijenata razvija se ciroza jetara ili primarni karcinom jetre. Rizik prijenosa infekcije s majke na dijete postoji kod majki s akutnom HBV infekcijom ili s kroničnim infektivnim statusom. Računa se s infekcijom djeteta u 70 - 80% ukoliko su u majke pozitivni HBs-Ag i HBe-Ag, dok je ovaj postotak daleko niži i iznosi svega 6% ukoliko je prisutan samo HBs-Ag. Najveći rizik prijenosa infekcije u trudnoći je sam porođaj. U našoj zemlji je obvezan probir trudnica na HBs-Ag.
Broj novozaraženih osoba teško je odrediti zbog velikog udjela bolesnika bez simptoma bolesti. Prema podacima Hrvatskog zavoda za javno zdravstvo Hrvatska spada u zemlje s niskom učestalosti hepatitisa B i rizik infekcije tijekom života iznosi 20-60%. Do zaraze najčešće dolazi u doba adolescencije ili u mlađoj odrasloj dobi. Infekcija se češće javlja kod: bolesnika koji su višekratno primili transfuzije krvi ili krvnih pripravaka prije 1993. godine, ovisnika o opojnim drogama, novorođenčadi majki s hepatitisom B, bolesnika na programu kronične hemodijalize, promiskuitetnih osoba, osoba u bliskom ili profesionalnom kontaktu s oboljelima.
Hepatitis B se javlja u akutnom ili kroničnom obliku. Većina zaraženih nema nikakvih simptoma što ne znači da bolest ne postoji. Simptomi akutne infekcije obično se javljaju nakon razdoblja inkubacije koji može potrajati između 50 - 150, u prosjeku 90 dana. Najčešće se javljaju nespecifični simptomi kao što su gubitak apetita, osjećaj slabosti i jakog umora, glavobolja, mučnine, povraćanje, bolovi ispod desnog rebarnog luka, osip ili bolovi u zglovima, a nakon 3-10 dana nastaje žutilo kože i bjeloočnica / žutica i tamno obojeni urin. S izbijanjem žutice, obično počinju popuštati drugi simptomi. Žutica je najintenzivnija nakon 1 - 2 tjedna, potom počinje faza ozdravljenja koja traje daljnjih 2 - 4 tjedna.
Jačina simptoma varira a uobičajeno se teži oblici bolesti javljaju u starijih pojedinaca. Vrlo rijetko tijek bolesti je toliko agresivan da uzrokuje akutno zatajenje jetre. Simptomi prestaju nakon eliminacije virusa što se kod većine zaraženih događa kroz tri mjeseca. U oko 5% odraslih virus zaostaje u organizmu dok je postotak puno veći (90%) ukoliko je do zaraze došlo prilikom poroda od majki s hepatitisom B. Ukoliko infekcija virusom hepatitisa B traje dulje od 6 mjeseci govorimo o kroničnom hepatitisu B. Simptomi su također nespecifični / umor i nelagoda ispod desnog rebarnog luka a bolest često postoji godinama prije negoli se slučajno otkrije.
Dijagnoza
Najpotpunija dijagnoza bolesti postavlja se nakon temeljitog pregleda bolesnika, putem rezultata krvnih pretraga i po mogućnosti učinjene biopsije jetre. Klinički pregled liječniku omogućuje pretraživanje znakova akutne ili kronične bolesti jetre. Uobičajeno se utvrđuje prisutnost osipa ili žutila kože, povećanje jetre ili slezene kao i nakupljanje suviška tekućine u tijelu.
Krvne pretrage obuhvaćaju testove jetrene funkcije te markere hepatitisa. Osnovni testovi određivanja jetrene funkcije mogu se odrediti u bilo kojem laboratoriju i obuhvaćaju alanin-aminotranferaze / ALT, aspartat-aminotransferazu / AST, bilirubin, albumin i protrombinsko vrijeme / PV. Normalni nalazi ne isključuju postojanje bolesti. Vrijednosti ALT-a i AST-a uobičajeno su blago povišene te su odraz trajno prisutne upalne aktivnosti. Izrazito visoke vrijednosti, oko 1,000 IU/L, uglavnom se viđaju u bolesnika s akutnom infekcijom. Tijekom kronične bolesti vrijednosti enzima variraju od normalnih do povišenih. Bilirubin se metabolizira u jetri a njegovo određivanje indirektno određuje stupanj oštećenja jetre. Povišeni bilirubin daje žutu boju kože i sluznica. Albumin i protrombinsko vrijeme odražavaju sintetsku funkciju jetre. Patološki nalazi viđaju se u bolesnika s težim stupnjem oštećenja kod akutne ili kronične infekcije.
Markeri hepatitisa služe za definitivnu potvrdu dijagnoze hepatitisa B i mogu se odrediti samo u specijaliziranim laboratorijima. Različiti su nivoi detekcije virusa i nije potrebno kod svih bolesnika raditi sve markere hepatitisa. Osnovnu dijagnostiku podrazumijeva serologija na hepatitis B dok se kod bolesnika s pozitivnim serološkim testom kao druga linija upotrebljava molekularna dijagnostika.
Biopsija jetre služi za kvalitativnu i kvantitativnu mikroskopsku procjenu stupnja bolesti. Može se naći široki spektar promjena, od minimalnih upalnih promjena do izrazito agresivnog hepatitisa sve do ciroze ili raka jetre. Podrazumijeva uzimanje uzorka tkiva jetre preko kože i zahtjeva 24-satni ostanak u bolnici. Često se kod bolesnika radi i kontrolna biopsija jetre, uobičajeno nakon 5 do 7 godina, posebno u neučinkovito liječenih.
U većini slučajeva nije potrebno specijalno liječenje, a specifični lijek protiv hepatitisa B ne postoji. Stoga se cijepljenje protiv hepatitisa B preporučuje svim osobama koje imaju povećani rizik, primjerice zdravstvenom osoblju. Prevencija bolesti se sastoji u davanju kombinacije imunoglobulina / Hepatitis B-imunoglobulin i cjepiva unutar 14 dana od ekspozicije. Trudnoća nije kontraindikacija za davanje cjepiva i imunoglobulina, a djeca majki koje su HBs-Ag i HBe-Ag pozitivne ili samo HBs-Ag pozitivne, dobivaju odmah po porodu i pasivnu i aktivnu zaštitu: imunoglobulin i cjepivo (HB-Vax K, Engerix K). U liječenju kroničnih formi hepatitisa B, ovisno o nizu kriterija, primjenjuje se interferonska terapija: interferon alfa 2b (Intron A) u visokim dozama koja u 10 - 30% odabranih slučajeva vodi do trajne eliminacije virusa. Noviji terapeutski pokušaji sastoje se u kombinaciji interferona i famciklovira, odnosno lamivudina. Kod fulminantnih oblika ne preostaje ništa drugo osim transplantacije jetre.
Ukoliko nema dodatnih komplikacija kod hepatitisa B, stroga hepatička dijeta, strogo mirovanje i strogo ograničavanje tjelesne aktivnosti nemaju dokazanu prednost u liječenju.
Cilj liječenja kronične infekcije je samo kontrola razmnožavanja virusa čime se pokušava kontrolirati stupanj oštećenja. Više je lijekova koji dokazano imaju antivirusni učinak i koriste se u liječenju hepatitisa B: lamivudin, adefovir, entekavir, telbivudin, konvencionalni i pegilirani interferon-alfa. Pristup liječenju izrazito je individualan, a odluku o načinu i trenutku liječenja poželjno je donijeti zajednički, u aktivnom odnosu bolesnik-liječnik. Svaki od navedenih lijekova ima brojne nuspojave te su tijekom liječenja potrebne redovite kontrole.
Prehrana
U prehrani se favorizira vegetarijanski način prehrane sa smanjenjem unosa masnoća, osobito životinjskog podrijetla, šećera i proteina, te porasta unosa biljnih vlakana u prehrani. Izbjegavati treba i druge namirnice životinjskog podrijetla, kofein, kola napici, čokolada, neke vrste čajeva, mineralna voda, brza hrana, zaslađeni voćni sokovi, umjetni zaslađivači i rafinirani šećeri.
Preporučuje se uporaba cjelovitih žitarica, smeđe riže, integralne i graham tjestenine, tunjevine, povrća, svih vrsta mahunarki i graha, većine prirodnih sokova, svježeg voća, proizvoda soje, maslinovog ulja. Najbolje povrće za jetra su mrkva i cikla koje sadrže obilje betakarotena, drugih karotenoida i flavonoida koji daju boju ovom povrću, a spadaju u antioksidativne tvari.
Od značaja može biti i maslačak s visokim sadržajem lecitina koji potpomaže metabolizam masnih tvari u jetri i smanjuje razinu endogenog kolesterola. Ne preporučuju se obilni obroci, radije 4 manja obroka, pri čemu bi zadnji obrok trebao biti barem 5 sati prije odlaska u krevet. Promjene u prehrani potrebno je postupno provoditi, korak po korak.
Sasvim je zabranjena uporaba alkohola, kao i drugih lijekova. U stimulaciji imunološkog odgovora značajnu ulogu igraju redukcija stresa, pravilan raspored dnevne aktivnosti i dnevnog odmora, ugodna dnevna rutina. Konstantno povoljan stimulirajući učinak na imunološki sustav pokazuju i preparati ehinaceje, koja potiče aktivaciju T-limfocita. Svakako je potrebno upozoriti partnera, kao i razjasniti njegov HBV status, odnosno poduzeti preventivno cijepljenje, a do tada se savjetuje zaštićeni spolni odnos.
Opće mjere liječenja obuhvaćaju cijepljenje protiv hepatitisa A te 1x godišnje cijepljenje protiv gripe. Nadalje, od posebne su važnosti i redovite kontrole bolesnika koji ne uzimaju terapiju a u cilju pravovremenog otkrivanja razvijene ciroze jetre kao i njezinih komplikacija, posebno raka jetre.
Prevencija
Obzirom na dostupno cjepivo i u Hrvatskoj je 1999. godine u obvezni program uvedeno cijepljenje protiv hepatitisa B. Mjere prevencije prijenosa infekcije unutar obitelji obuhvaćaju zaštitu prilikom rukovanja zaraženim oštrim predmetima, testiranje ukućana te procjepljivanje necijepljenih članova.
dr. Vesna Harni